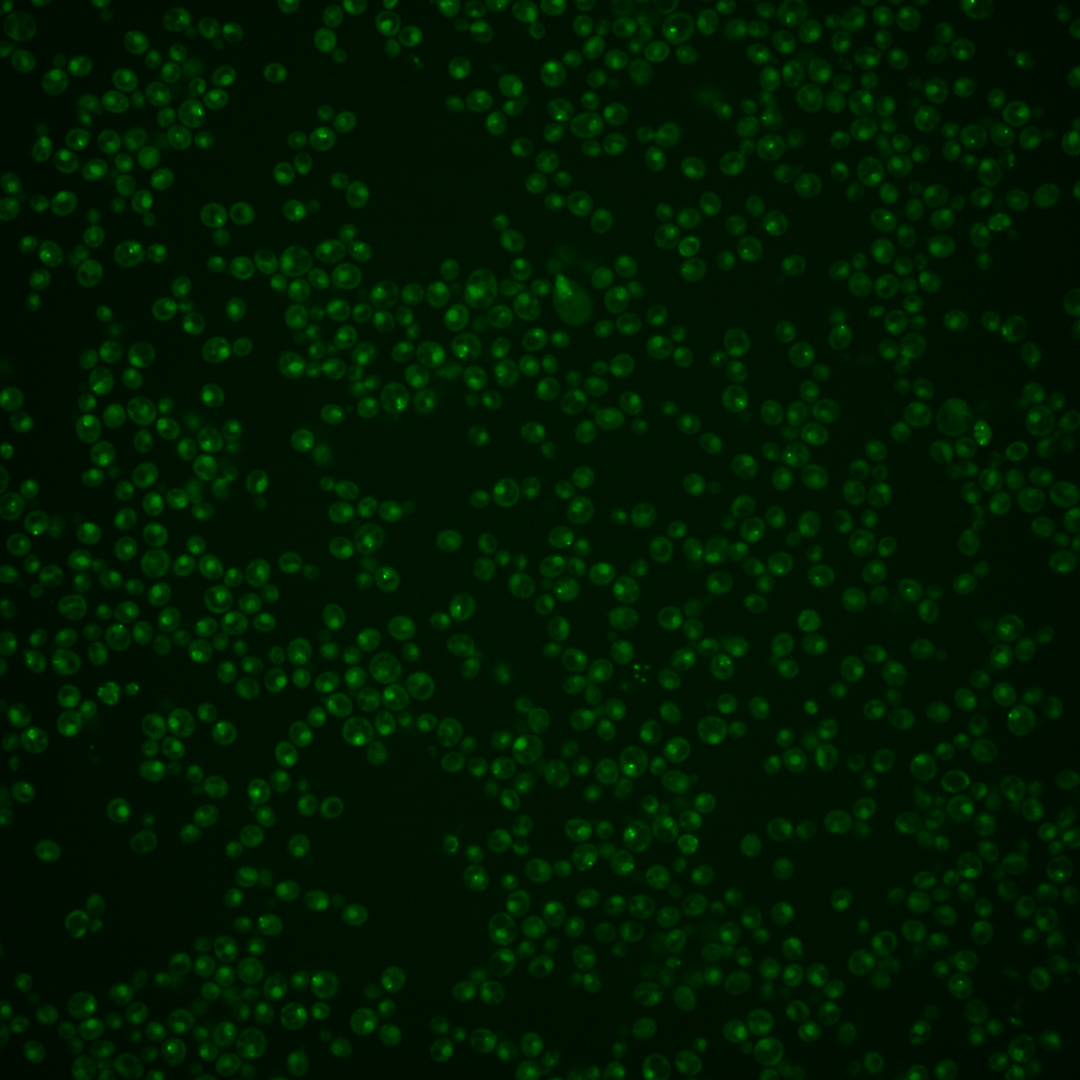

| Standard name | |
|---|---|
| Human Ortholog | |
| Description | Subunit of the Anaphase-Promoting Complex/Cyclosome (APC/C); APC/C is a ubiquitin-protein ligase required for degradation of anaphase inhibitors, including mitotic cyclins, during the metaphase/anaphase transition; component of the platform domain of the APC/C, based on structural analysis; relative distribution to nuclear foci decreases upon DNA replication stress |
Micrographs




















































































Sub-cellular Localization
Yeast GFP Assignment
Protein Abundance
Localization Change
External localization resources
| ensLOC | DeepLoc | |||||||||||||||||||||||
|---|---|---|---|---|---|---|---|---|---|---|---|---|---|---|---|---|---|---|---|---|---|---|---|---|
| Localization | WT1 | WT2 | WT3 | RAP60 | RAP140 | RAP220 | RAP300 | RAP380 | RAP460 | RAP540 | RAP620 | RAP700 | HU80 | HU120 | HU160 | rpd3Δ_1 | rpd3Δ_2 | rpd3Δ_3 | WT1 | WT2 | WT3 | AF100 | AF140 | AF180 |
| Cortical Patches | 0 | 0 | 0 | 0 | 0 | 0 | 0 | – | 0 | 0 | 0 | 1 | 0 | 0 | 0 | 0 | 0 | 0 | 0 | 0 | 1 | 0 | 0 | 0 |
| Bud | 0 | 1 | 0 | 1 | 1 | 0 | 1 | – | 4 | 5 | 8 | 4 | 0 | 0 | 0 | 0 | 0 | 0 | 5 | 7 | 3 | 1 | 3 | 4 |
| Bud Neck | 0 | 0 | 0 | 2 | 0 | 1 | 2 | – | 1 | 4 | 2 | 0 | 0 | 2 | 0 | 0 | 0 | 0 | 0 | 2 | 1 | 0 | 0 | 1 |
| Bud Site | 0 | 0 | 0 | 1 | 0 | 5 | 4 | – | 5 | 6 | 13 | 9 | 0 | 0 | 0 | 0 | 0 | 0 | – | – | – | – | – | – |
| Cell Periphery | 0 | 0 | 0 | 0 | 0 | 0 | 0 | – | 0 | 0 | 0 | 0 | 0 | 0 | 0 | 1 | 0 | 1 | 0 | 0 | 0 | 0 | 0 | 0 |
| Cytoplasm | 7 | 20 | 22 | 20 | 14 | 23 | 38 | – | 34 | 26 | 35 | 46 | 29 | 42 | 63 | 15 | 31 | 18 | 1 | 7 | 6 | 7 | 7 | 11 |
| Endoplasmic Reticulum | 1 | 1 | 0 | 1 | 0 | 0 | 0 | – | 0 | 0 | 0 | 0 | 0 | 0 | 1 | 5 | 13 | 3 | 0 | 0 | 1 | 0 | 0 | 0 |
| Endosome | 14 | 28 | 15 | 6 | 6 | 15 | 7 | – | 4 | 5 | 4 | 12 | 13 | 26 | 42 | 17 | 49 | 25 | 14 | 23 | 6 | 0 | 3 | 8 |
| Golgi | 0 | 0 | 1 | 0 | 0 | 0 | 0 | – | 0 | 0 | 0 | 1 | 0 | 1 | 0 | 0 | 4 | 2 | 0 | 1 | 2 | 0 | 1 | 0 |
| Mitochondria | 24 | 7 | 0 | 4 | 5 | 38 | 42 | – | 105 | 101 | 177 | 102 | 2 | 2 | 0 | 9 | 10 | 8 | 7 | 4 | 3 | 2 | 8 | 9 |
| Nucleus | 225 | 219 | 103 | 49 | 43 | 75 | 75 | – | 117 | 83 | 98 | 80 | 103 | 129 | 98 | 83 | 105 | 84 | 194 | 206 | 98 | 109 | 145 | 180 |
| Nuclear Periphery | 3 | 2 | 0 | 0 | 0 | 0 | 1 | – | 0 | 1 | 1 | 0 | 0 | 1 | 0 | 0 | 1 | 0 | 1 | 1 | 2 | 0 | 0 | 0 |
| Nucleolus | 31 | 50 | 12 | 16 | 18 | 31 | 21 | – | 17 | 14 | 11 | 10 | 18 | 36 | 43 | 25 | 27 | 21 | 15 | 19 | 16 | 1 | 6 | 13 |
| Peroxisomes | 0 | 0 | 1 | 0 | 0 | 3 | 0 | – | 0 | 0 | 0 | 0 | 2 | 0 | 3 | 1 | 2 | 2 | 0 | 0 | 0 | 0 | 0 | 0 |
| SpindlePole | 11 | 37 | 14 | 31 | 38 | 49 | 34 | – | 23 | 16 | 14 | 25 | 21 | 50 | 53 | 31 | 34 | 35 | 31 | 65 | 26 | 2 | 5 | 14 |
| Vac/Vac Membrane | 16 | 43 | 9 | 5 | 11 | 11 | 10 | – | 13 | 20 | 22 | 25 | 7 | 9 | 11 | 19 | 24 | 27 | 23 | 29 | 24 | 17 | 33 | 58 |
| Unique Cell Count | 278 | 334 | 159 | 110 | 112 | 195 | 188 | 250 | 217 | 269 | 240 | 167 | 242 | 250 | 169 | 226 | 173 | 300 | 376 | 205 | 147 | 222 | 310 | |
| Labelled Cell Count | 332 | 408 | 177 | 136 | 136 | 251 | 235 | 323 | 281 | 385 | 315 | 195 | 298 | 314 | 206 | 300 | 226 | 300 | 376 | 205 | 147 | 222 | 310 | |
Yeast GFP Assignment
Protein Abundance
| Screen | WT1 | WT2 | WT3 | RAP60 | RAP140 | RAP220 | RAP300 | RAP380 | RAP460 | RAP540 | RAP620 | RAP700 | HU80 | HU120 | HU160 | rpd3Δ_1 | rpd3Δ_2 | rpd3Δ_3 | AF100 | AF140 | AF180 |
|---|---|---|---|---|---|---|---|---|---|---|---|---|---|---|---|---|---|---|---|---|---|
| Mean Cell GFP Intensity (1e-4) | 4.9 | 6.0 | 6.8 | 6.6 | 6.2 | 5.3 | 5.8 | – | 4.4 | 4.6 | 4.1 | 4.7 | 6.2 | 6.2 | 6.1 | 6.9 | 7.2 | 6.6 | 5.4 | 6.1 | 6.1 |
| Std Deviation (1e-4) | 0.8 | 0.9 | 2.1 | 2.8 | 2.2 | 2.0 | 2.9 | – | 1.2 | 1.3 | 1.4 | 1.8 | 1.3 | 1.3 | 1.5 | 1.2 | 1.9 | 1.4 | 1.3 | 1.5 | 1.5 |
| Intensity Change (Log2) | – | – | – | -0.04 | -0.13 | -0.37 | -0.22 | – | -0.63 | -0.56 | -0.72 | -0.54 | -0.13 | -0.14 | -0.15 | 0.02 | 0.08 | -0.05 | -0.32 | -0.16 | -0.15 |
Localization Change
| Localization | RAP60 | RAP140 | RAP220 | RAP300 | RAP380 | RAP460 | RAP540 | RAP620 | RAP700 | HU80 | HU120 | HU160 | rpd3Δ_1 | rpd3Δ_2 | rpd3Δ_3 |
|---|---|---|---|---|---|---|---|---|---|---|---|---|---|---|---|
| Cortical Patches | 0 | 0 | 0 | 0 | – | 0 | 0 | 0 | 0 | 0 | 0 | 0 | 0 | 0 | 0 |
| Bud | 0 | 0 | 0 | 0 | – | 0 | 0 | 0 | 0 | 0 | 0 | 0 | 0 | 0 | 0 |
| Bud Neck | 0 | 0 | 0 | 0 | – | 0 | 0 | 0 | 0 | 0 | 0 | 0 | 0 | 0 | 0 |
| Bud Site | 0 | 0 | 0 | 0 | – | 0 | 0 | 0 | 0 | 0 | 0 | 0 | 0 | 0 | 0 |
| Cell Periphery | 0 | 0 | 0 | 0 | – | 0 | 0 | 0 | 0 | 0 | 0 | 0 | 0 | 0 | 0 |
| Cytoplasm | 1.0 | -0.3 | -0.6 | 1.6 | – | -0.1 | -0.5 | -0.2 | 1.4 | 0.9 | 0.9 | 2.8 | -1.4 | 0 | -1.0 |
| Endoplasmic Reticulum | 0 | 0 | 0 | 0 | – | 0 | 0 | 0 | 0 | 0 | 0 | 0 | 0 | 3.1 | 0 |
| Endosome | -1.2 | -1.2 | -0.6 | -2.2 | – | 0 | 0 | 0 | 0 | -0.5 | 0.4 | 2.1 | 0.2 | 3.2 | 1.4 |
| Golgi | 0 | 0 | 0 | 0 | – | 0 | 0 | 0 | 0 | 0 | 0 | 0 | 0 | 0 | 0 |
| Mitochondria | 0 | 0 | 5.9 | 6.4 | – | 0 | 0 | 0 | 0 | 0 | 0 | 0 | 0 | 0 | 0 |
| Nucleus | -3.3 | -4.3 | -4.9 | -4.6 | – | -3.6 | -5.1 | -5.7 | -6.2 | -0.6 | -2.3 | -5.0 | -2.9 | -3.6 | -3.0 |
| Nuclear Periphery | 0 | 0 | 0 | 0 | – | 0 | 0 | 0 | 0 | 0 | 0 | 0 | 0 | 0 | 0 |
| Nucleolus | 1.8 | 2.2 | 2.4 | 1.1 | – | 0 | 0 | 0 | 0 | 1.0 | 2.2 | 2.8 | 2.1 | 1.4 | 1.4 |
| Peroxisomes | 0 | 0 | 0 | 0 | – | 0 | 0 | 0 | 0 | 0 | 0 | 0 | 0 | 0 | 0 |
| SpindlePole | 4.2 | 5.2 | 4.0 | 2.5 | – | 0 | 0 | 0 | 0 | 1.1 | 3.2 | 3.3 | 2.5 | 1.8 | 2.9 |
| Vacuole | -0.4 | 1.3 | 0 | -0.1 | – | -0.2 | 1.3 | 1.0 | 1.7 | -0.6 | -0.9 | -0.6 | 1.8 | 1.7 | 2.9 |
External localization resources
Images






























Protein Concentration and Protein Localization Data
| R1 | R2 | R3 | ||||||||||||||||
|---|---|---|---|---|---|---|---|---|---|---|---|---|---|---|---|---|---|---|
| G1 Pre-START | G1 Post-START | S/G2 | Metaphase | Anaphase | Telophase | G1 Pre-START | G1 Post-START | S/G2 | Metaphase | Anaphase | Telophase | G1 Pre-START | G1 Post-START | S/G2 | Metaphase | Anaphase | Telophase | |
| Concentration | -0.1943 | 0.2273 | -0.4724 | -0.2205 | -0.5838 | -0.2107 | -0.0466 | 0.3747 | 0.3338 | -0.096 | -0.1574 | 0.3368 | 0.4746 | 0.8379 | 0.7415 | 0.8533 | 0.3398 | 0.7438 |
| Actin | 0.0204 | 0.0006 | 0.0015 | 0.0051 | 0.0155 | 0.0018 | 0.0061 | 0.0004 | 0.0006 | 0.0114 | 0.0031 | 0.0015 | 0.0005 | 0 | 0.0002 | 0 | 0.0019 | 0.0001 |
| Bud | 0.0005 | 0.0001 | 0.001 | 0.0006 | 0.0007 | 0.0001 | 0.0001 | 0.0029 | 0.0001 | 0.0004 | 0.0005 | 0.0001 | 0.0013 | 0.0001 | 0 | 0 | 0.0001 | 0 |
| Bud Neck | 0.007 | 0.0018 | 0.0027 | 0.0008 | 0.0024 | 0.0067 | 0.0039 | 0.0009 | 0.0038 | 0.007 | 0.001 | 0.0033 | 0.0004 | 0.0013 | 0.0009 | 0.0009 | 0.0007 | 0.0026 |
| Bud Periphery | 0.0007 | 0.0001 | 0.0013 | 0.0015 | 0.0007 | 0.0003 | 0.0001 | 0.0006 | 0.0001 | 0.0005 | 0.0013 | 0.0003 | 0.0003 | 0 | 0 | 0 | 0.0002 | 0 |
| Bud Site | 0.0105 | 0.0012 | 0.0084 | 0.0009 | 0.0025 | 0.0003 | 0.0005 | 0.0018 | 0.0063 | 0.0043 | 0.0012 | 0.0002 | 0.0002 | 0.0007 | 0.0004 | 0.0005 | 0.0001 | 0.0001 |
| Cell Periphery | 0.0004 | 0.0001 | 0.0002 | 0.0001 | 0.0001 | 0.0001 | 0.0001 | 0.0001 | 0.0001 | 0.0002 | 0.0002 | 0 | 0 | 0 | 0 | 0 | 0 | 0 |
| Cytoplasm | 0.0223 | 0.027 | 0.0193 | 0.0372 | 0.0364 | 0.0286 | 0.0185 | 0.02 | 0.0102 | 0.0075 | 0.0086 | 0.0121 | 0.009 | 0.0122 | 0.0082 | 0.008 | 0.0012 | 0.0079 |
| Cytoplasmic Foci | 0.0504 | 0.0112 | 0.0189 | 0.0035 | 0.0151 | 0.0033 | 0.0143 | 0.0029 | 0.0075 | 0.0164 | 0.0068 | 0.0031 | 0.0033 | 0.0012 | 0.0027 | 0.0063 | 0.0013 | 0.0005 |
| Eisosomes | 0.0002 | 0.0003 | 0.0001 | 0.0002 | 0.0001 | 0 | 0.0002 | 0 | 0 | 0.0003 | 0.0001 | 0 | 0 | 0 | 0 | 0 | 0 | 0 |
| Endoplasmic Reticulum | 0.0021 | 0.0018 | 0.0013 | 0.0017 | 0.0019 | 0.0022 | 0.0013 | 0.0009 | 0.0003 | 0.0016 | 0.0009 | 0.0021 | 0.0006 | 0.0004 | 0.0003 | 0.0004 | 0.0005 | 0.0002 |
| Endosome | 0.0345 | 0.0076 | 0.0145 | 0.0109 | 0.0168 | 0.01 | 0.011 | 0.0027 | 0.0027 | 0.0197 | 0.0174 | 0.009 | 0.0023 | 0.0016 | 0.0011 | 0.0193 | 0.008 | 0.0005 |
| Golgi | 0.0097 | 0.0008 | 0.0049 | 0.0033 | 0.0197 | 0.0022 | 0.0058 | 0.0002 | 0.0008 | 0.0062 | 0.0081 | 0.0031 | 0.0002 | 0.0001 | 0.0002 | 0.0006 | 0.0051 | 0 |
| Lipid Particles | 0.0467 | 0.0198 | 0.0055 | 0.0033 | 0.0289 | 0.0042 | 0.0128 | 0.0016 | 0.0025 | 0.0168 | 0.015 | 0.0062 | 0.0015 | 0.0025 | 0.0015 | 0.0011 | 0.0083 | 0.0002 |
| Mitochondria | 0.0173 | 0.0004 | 0.003 | 0.0841 | 0.0193 | 0.0079 | 0.0045 | 0.0006 | 0.0005 | 0.0016 | 0.0506 | 0.0025 | 0.0007 | 0.0003 | 0.0001 | 0.0004 | 0.0033 | 0.0001 |
| None | 0.028 | 0.1055 | 0.031 | 0.0331 | 0.0154 | 0.0264 | 0.0309 | 0.0363 | 0.0489 | 0.0425 | 0.0628 | 0.0545 | 0.0121 | 0.0046 | 0.0144 | 0.0019 | 0.0003 | 0.0035 |
| Nuclear Periphery | 0.0203 | 0.0311 | 0.02 | 0.0323 | 0.0197 | 0.0278 | 0.025 | 0.0282 | 0.0233 | 0.0141 | 0.02 | 0.0213 | 0.0109 | 0.0155 | 0.023 | 0.0111 | 0.0041 | 0.0044 |
| Nucleolus | 0.0166 | 0.0556 | 0.0368 | 0.0117 | 0.0207 | 0.0383 | 0.0321 | 0.0497 | 0.0281 | 0.0104 | 0.0096 | 0.0389 | 0.0265 | 0.0616 | 0.0386 | 0.0356 | 0.0285 | 0.0561 |
| Nucleus | 0.4076 | 0.401 | 0.3864 | 0.5934 | 0.7042 | 0.6809 | 0.6042 | 0.5217 | 0.4461 | 0.4572 | 0.5751 | 0.6462 | 0.5424 | 0.5778 | 0.4006 | 0.717 | 0.7378 | 0.7072 |
| Peroxisomes | 0.0185 | 0.0008 | 0.0013 | 0.007 | 0.0121 | 0.0006 | 0.0096 | 0.0002 | 0.0016 | 0.0096 | 0.0043 | 0.0011 | 0.0015 | 0.0001 | 0.0002 | 0.0002 | 0.0005 | 0 |
| Punctate Nuclear | 0.2766 | 0.331 | 0.4392 | 0.1653 | 0.0651 | 0.1559 | 0.2172 | 0.3271 | 0.4153 | 0.3706 | 0.2086 | 0.1929 | 0.3854 | 0.3179 | 0.5071 | 0.1939 | 0.197 | 0.2162 |
| Vacuole | 0.0083 | 0.0016 | 0.0025 | 0.0023 | 0.0018 | 0.0016 | 0.0011 | 0.0009 | 0.0007 | 0.001 | 0.0024 | 0.0009 | 0.0007 | 0.0019 | 0.0003 | 0.0022 | 0.0004 | 0.0002 |
| Vacuole Periphery | 0.0014 | 0.0006 | 0.0005 | 0.0019 | 0.0011 | 0.0009 | 0.0005 | 0.0004 | 0.0005 | 0.0005 | 0.0021 | 0.0005 | 0.0003 | 0.0004 | 0.0002 | 0.0006 | 0.0004 | 0 |
Sequencing Data
| R1 | R2 | |||||||||
|---|---|---|---|---|---|---|---|---|---|---|
| G1 Post-START | S/G2 | Metaphase | Anaphase | Telophase | G1 Post-START | S/G2 | Metaphase | Anaphase | Telophase | |
| Gene Expression | 5.0935 | 6.71 | 7.4687 | 7.996 | 4.5185 | 3.2151 | 7.5114 | 7.8499 | 7.5122 | 7.7533 |
| Translational Efficiency | 0.5329 | 0.4684 | 0.4435 | 0.4639 | 0.6482 | 0.7789 | 0.4834 | 0.4091 | 0.3937 | 0.4464 |
Hit Data
| Dataset | Hit |
|---|---|
| Protein Concentration | ✘ |
| Protein Localization | ✔ |
| Gene Expression | ✔ |
| Translational Efficiency | ✘ |
Endocytosis
| Temp | Actin Patch (Sac6-tdTomato) | Cortical Patch (Sla1-GFP) | Late Endosome (Snf7-GFP) | Vacuole (Vph1-GFP) |
|---|---|---|---|---|
| 37℃ | ||||
| RT |
Cell Cycle Omics
CYCLoPs (Apc5-GFP)
| Gene / Allele | Actin Patch (Sac6-tdTomato) | Cortical Patch (Sla1-GFP) | Late Endosome (Snf7-GFP) | Vacuole (Sac6-tdTomato) |
|---|
| Gene | Images |
|---|
| Gene | Images |
|---|
Images are not yet available
Images are not yet available